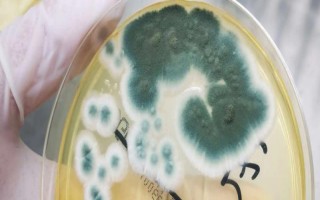
食用菌青霉菌的发生症状，会分泌毒素造成食用菌菌丝死亡
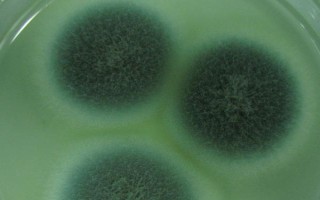
食用菌青霉菌的发生症状，会分泌毒素造成食用菌菌丝死亡

形态特征,是民间对某些剧毒胡蜂的俗称
某些剧毒胡蜂在民间俗称为“人头蜂”(非正式学名),因为这些胡蜂具有极强的毒性,常致人死亡,因此被冠上了这个称谓。被叫做人头蜂的胡蜂品种,包括金环胡蜂、黄脚胡蜂、黄腰胡蜂、黑尾胡蜂等。一、称谓来源1、人...
05-31
培养料里面出现青霉菌时,刚开始菌丝呈白色,菌落接近圆形至不规则形,外观近似粉末。孢子经过繁殖后,菌落会逐渐变成蓝色、绿色。
菌落边缘呈白色,老菌落的表面会出现膜状物,而且会分泌毒素,危害食用菌的菌丝。
培养食用菌期间,如果情况很严重,会导致菌种失去价值,发菌期也无法出菇。
1、在培养料发生青霉菌时,它的菌丝初期呈白色,菌落近圆形至不定形,外观略呈粉末状,而随着孢子大量繁殖,它的菌落颜色会由白色转变为蓝色或者绿色,这也是它蓝绿霉名字由来。
2、菌落边缘呈白色,扩展较慢,而老菌落表面会交织形成一层膜状物,直接覆盖在培养料上,还会分泌毒素造成食用菌菌丝死亡。
3、在食用菌培养过程中,严重时会造成菌种报废,发菌期可能会到局部料面不出菇。
1、青霉菌均属半知菌青霉菌真菌,病菌在生长过程中菌落呈蓝绿色,病菌分布广泛,多腐生或弱寄生。
2、在食用菌栽培过程中主要是通过气流传入培养料,进行初次侵染,而带菌的原料也是栽培过程中最重要的侵染源。
3、侵染后,它的分生孢子会借借气流、昆虫、人工喷水和管理操作进行再浸染。
4、在28-30℃的温度环境最易发生,分生孢子短时间内就会形成菌丝,并迅速繁殖更多的分生孢子,大多数的青霉菌喜欢酸性环境,所以在培养料及覆土呈酸性较易发病。

1、首先要做好接种室、培养室以及生产场所的消毒灭菌光照,保持环境干净死亡,加强通风换气,以免病菌蔓延。
2、再就是要调整好培养料的酸碱度,将其调节至偏碱性,在采菇后喷洒石灰水,刺激食用菌菌丝生长,抑制青霉菌发生。

3、袋装栽培局部发生时,可以注射15%甲醛溶液;椴木栽培时可以用石灰水洗刷;菇床山高富帅是用1%克霉灵、0.5%多丰农、0.1%施保功和0.1%扑海因溶液喷洒防治。
标签: 食用菌青霉菌的发生症状
相关文章
某些剧毒胡蜂在民间俗称为“人头蜂”(非正式学名),因为这些胡蜂具有极强的毒性,常致人死亡,因此被冠上了这个称谓。被叫做人头蜂的胡蜂品种,包括金环胡蜂、黄脚胡蜂、黄腰胡蜂、黑尾胡蜂等。一、称谓来源1、人...
05-31
未对折的子线,长度多为20-50厘米,对折后保持10-25厘米即可,双钩的间距以2-3个钩距为宜。比如36厘米的子线,绑4号袖钩对折后,上钩子线和下钩子线的长度分别为17厘米、19厘米左右,双钩的间距...
10-01
防治措施:选用抗病性能良好的种子,播种前可以使用0.1%高锰酸钾溶液浸种5-6小时,浸种后用清水冲洗数遍后催芽播种,可有效防止。也可实施合理轮作,科学施肥,实行高畦种植或加强田间管理和药剂防治等方法。...
04-10
独头蒜和普通大蒜在外观形态以及价值方面有一定出入。外观形态:独头蒜仅仅只有一个蒜瓣,而普通大蒜由多瓣蒜瓣组成。价值:独头蒜产量少,价格比普通大蒜高,同时独头蒜中的大蒜素含量更高,蒜味更浓,抑菌效果也更...
08-19
1、西梅果皮呈深紫色,果肉呈琥珀色,原产地为法国西南部地区。2、1856年,西梅引入北美地区,直至1900年,加州地区的西梅种植面积已达9万公顷,且该地的西梅产出量超过世界其他各地的西梅总产量(加州西...
07-14
清洗干净:将风信子球茎表面的土壤清洗干净,然后除去腐烂部位并使用多菌灵消毒,最后置于通风处晾干。保存:将风信子种球埋入湿润沙土中保存,保存环境要求通风阴凉。3-4个月后,从沙土中取出球茎准备种植。或者...
11-25
完全喜阴的室内大型植物有一叶兰、苹果竹芋、琴叶榕、龙血树、散尾葵等。一叶兰:一叶兰耐阴性极强,叶片挺拔整齐、叶色翠绿,是一种优良室内观叶植物。苹果竹芋:苹果竹芋株型大气优雅,叶片宽大、叶色翠绿,耐阴性...
09-22
雏鹅啄壳后,如果达到20小时以上还未出壳,则要帮助它剥壳。雏鹅出壳后,要让鹅舍保持适温,防止它们因聚堆取暖而被踩死。雏鹅出壳后,根据它们的年龄保持恒温即可。7日龄以内,将温度保持在33℃。7日龄之后,...
12-11
在0℃以下的环境中,蚯蚓会被冻死,在0-5℃的环境中它们会休眠。蚯蚓不耐高温,温度超过32℃就会停止生长,超过40℃就会死亡。温度为5-30℃时,蚯蚓会正常活动,20-27℃左右是它们的活动和孵化适温...
01-29
夜钓适合用什么饵料取决于垂钓对象。鲫鱼:荤素皆食,荤饵包括蚯蚓、红虫、肉蛆等。素饵包括自制饵和商品饵,比如饭粒、玉米、面粉、胡豆粉、疯钓鲫、野战蓝鲫等。鲤鱼:荤素皆食,素饵包括马铃薯、嫩玉米粒、酒泡小...
10-29
热点文章
林蛙如何区分公母,是同一个品种
宇翔9号玉米栽培技术要点,普通玉米品种
九圣禾M138棉花栽培技术要点,播种时亩施底肥50千克复合肥
中棉EB001棉花栽培技术要点,夏播生育期94天
天隆优717水稻栽培技术要点,粳型杂交水稻品种
犬猫自身免疫性溶血性贫血治疗方案,常表现为精神沉郁且不愿活动
氟磺胺草醚可以打哪些作物,在土壤中的残留期较长
红头鱼为什么便宜,是鲉形目鲂鮄科红娘鱼属的鱼